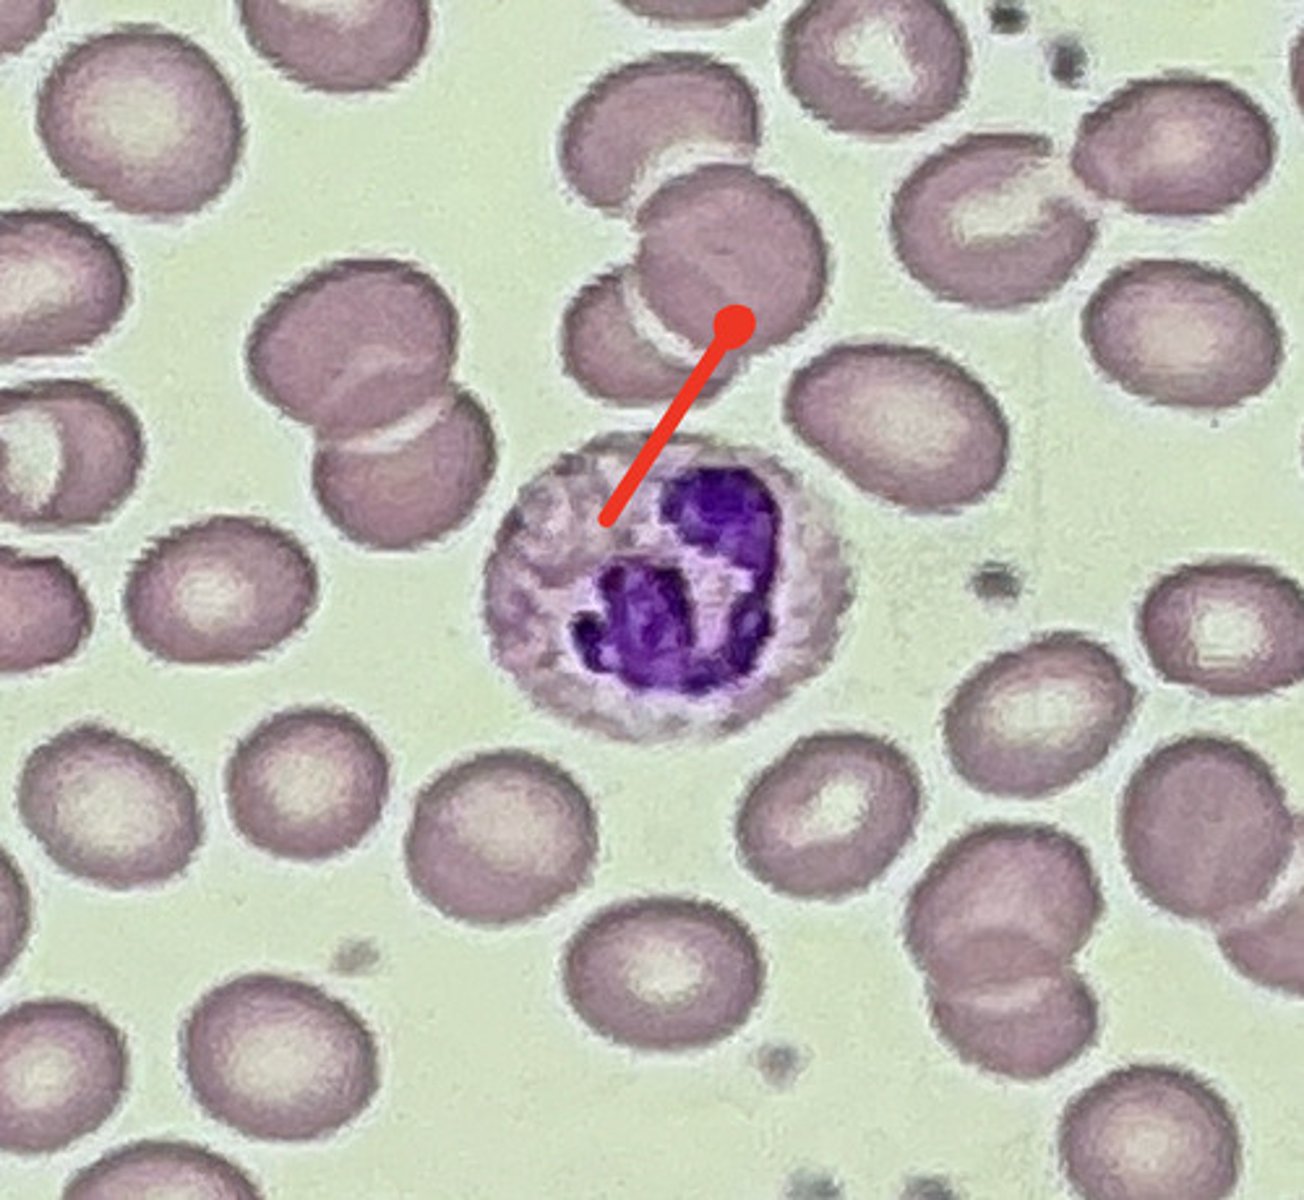
knowt flashcard image
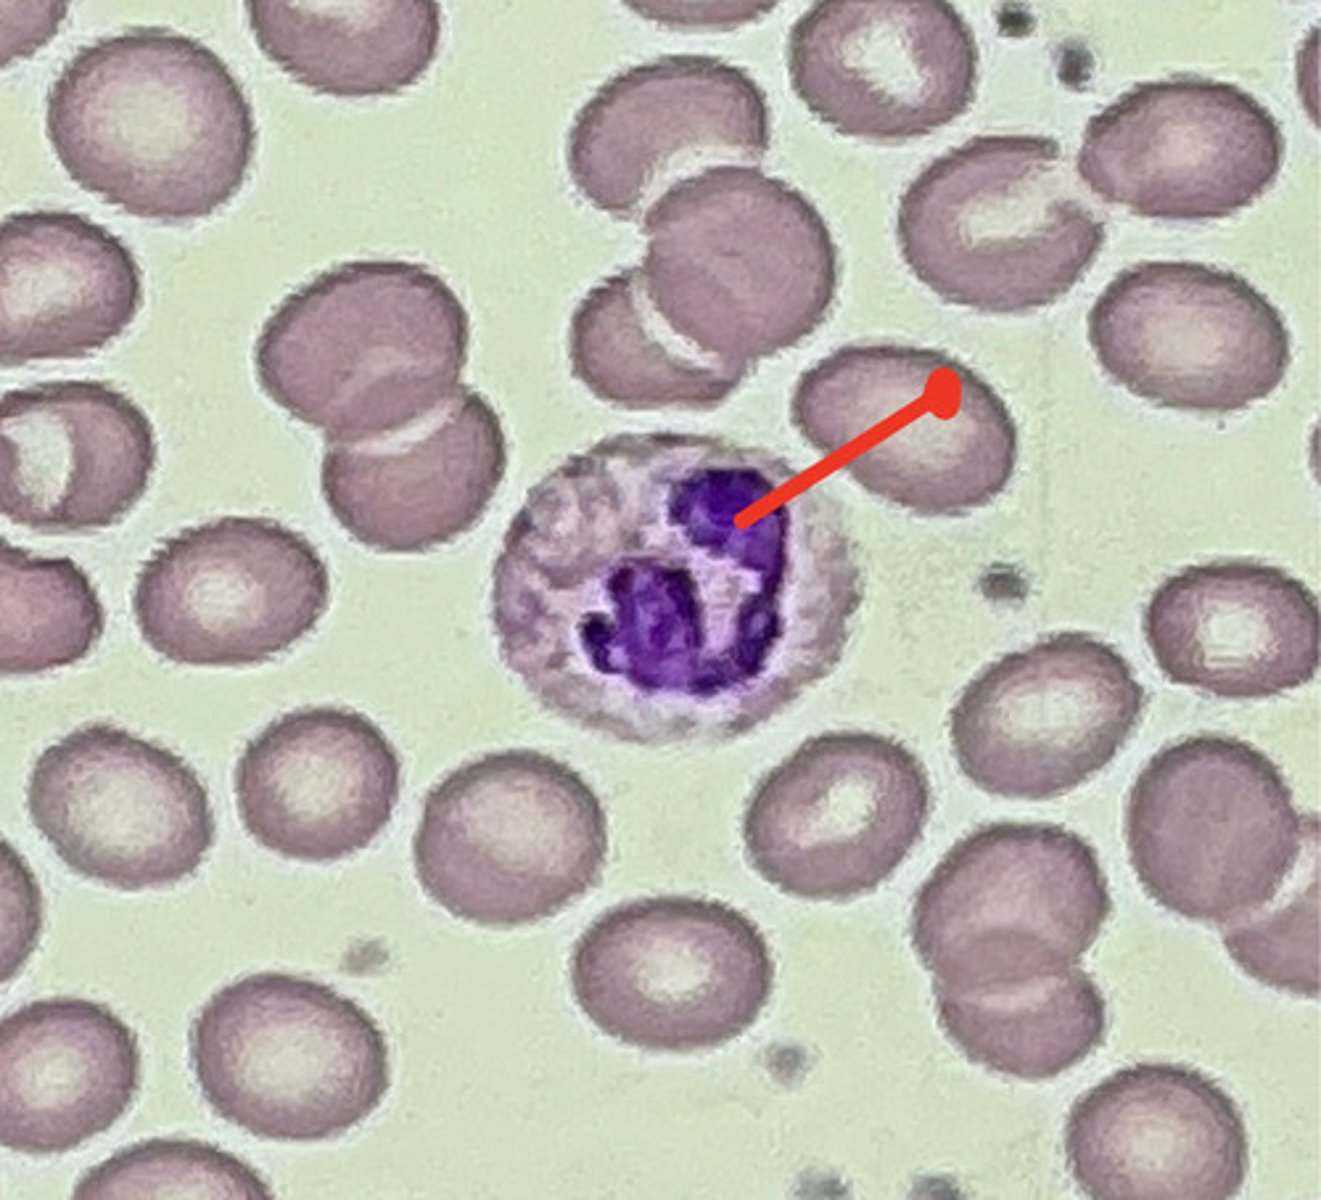
knowt flashcard image

Cell Anatomy Microscope Slides
0.0(0)
0.0(0)
Card Sorting
1/23
There's no tags or description
Looks like no tags are added yet.
Study Analytics
Name | Mastery | Learn | Test | Matching | Spaced | Call with Kai |
|---|
No study sessions yet.
24 Terms
1
New cards
Plasma Membrane

2
New cards
Plasma Membrane

3
New cards
Cytoplasm

4
New cards
Cytoplasm
5
New cards
Nucleus
6
New cards
Nucleus

7
New cards
Nucleus

8
New cards
Nucleolus

9
New cards
Mitochondria

10
New cards
Rough Endoplasmic Reticulum

11
New cards
Golgi Aparatus

12
New cards
Ribosomes

13
New cards
Centriole

14
New cards
Microvilli

15
New cards
Microvilli

16
New cards
Microvilli

17
New cards
Centriole

18
New cards
Prophase

19
New cards
Metaphase

20
New cards
Anaphase

21
New cards
Cilia

22
New cards
Cilia

23
New cards
Telophase

24
New cards
Still learning (2)
You've started learning these terms. Keep it up!